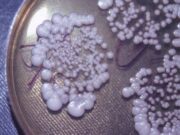
Молочница

Болезни и лекарства
Как действует препарат Колдрекс ?
Часто случается так, что под вечер появляется ощущение «расклеенности», озноб, першение в горле, свербит в носу. Ко всему подключается головная боль и общая слабость,...
Йога вместо таблеток
Йога – это система упражнений, которая помогает человеку обрести крепкое здоровье, внутреннюю гармонию и счастье. Она помогает достигать поставленных целей и укрепляет дух. Йога...
Parasept : педикулицидное средство с новейшей формулой
Как избавиться от вшей и гнид, если они завелись в волосах? Этот вопрос задают многие люди, столкнувшиеся с данной проблемой. Многие люди пользуются одним...
Методы лечения эрозии шейки матки
Эрозия шейки матки представляет собой заболевание, характеризующееся повреждением плоского эпителия, который располагается вокруг наружного зева на части влагалища, что находится снаружи. Такое заболевание может...
Ветмедин: современное лекарственное средство для лечения сердечной недостаточности у собак
Для любителей домашних животных любой питомец считается членом семьи. И конечно же каждый хозяин переживает, когда его питомец болен и старается помочь как можно...
Керамическая плитка: популярный отделочный материал
Если вы решили сделать красивую и надежную отделку в своем доме, тогда обратите внимание на популярный материал для отделки – керамическую плитку. Интернет-магазины, которые...
Молочница
Молочница (кандидоз) может поражать влагалище, рот, кожу, а у мужчин — головку полового члена. Этот раздел посвящен кандидозу влагалища. Прочитайте подробнее, в чем особенность молочницы у мужчин, а также про молочницу полости...
Депрессия
Депрессия — это больше, чем просто тоска или усталость от жизни в течение нескольких дней. Каждый из нас знает, что такое плохое настроение. Но когда речь идет о депрессии, вам...
Грыжи: основные виды и лечение
Грыжа — это выпячивание органа или его части через отверстие в окружающих тканях.
Грыжа позвоночника (межпозвоночная грыжа, грыжа диска) — это распространенное заболевание, которое чаще развивается на фоне...
Фотодинамическая терапия в онкологии: особенности метода
Лечение рака включает в себя множество новейших методов и технологий, которые комбинируются для получения оптимального результата. Хотя традиционные методы, такие как химиотерапия, лучевая терапия...